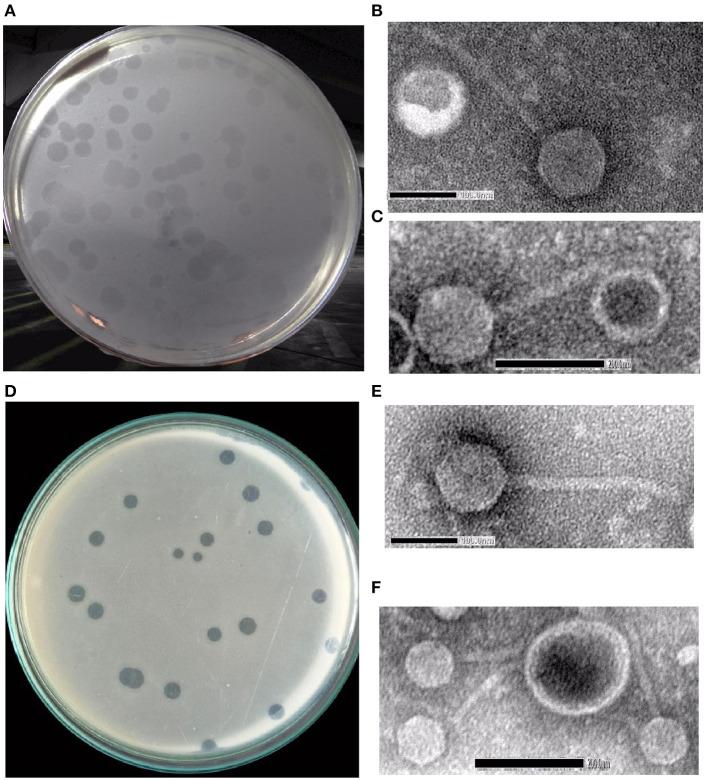
https://cdn.ncbi.nlm.nih.gov/pmc/blobs/6577/10716491/a8dc9f3ed62b/fmicb-14-1240570-g0001.jpg

新型广谱裂解性噬菌体的特性及其对耐多药菌的感染作用,以及它们在生鸡肉上的应用以减少菌载量。
Characterizations of novel broad-spectrum lytic bacteriophages and infecting MDR spp. with their application on raw chicken to reduce the load.
作者信息
Ahamed S K Tousif, Rai Srijana, Guin Chiranjib, Jameela Rameez Moidu, Dam Somasri, Muthuirulandi Sethuvel Dhiviya Prabaa, Balaji V, Giri Nabanita
机构信息
Department of Microbiology, Acharya Prafulla Chandra College, New Barrackpore, Kolkata, India.
Department of Microbiology, Bose Institute, Kolkata, West Bengal, India.
出版信息
Front Microbiol. 2023 Nov 29;14:1240570. doi: 10.3389/fmicb.2023.1240570. eCollection 2023.
The evidence and prevalence of multidrug-resistant (MDR) spp. poses a serious global threat to public health and the economy. Food- or water-borne MDR spp. demands an alternate strategy to counteract this threat. In this regard, phage therapy has garnered great interest from medical practitioners and researchers as a potential way to combat MDR pathogens. In this observation, we isolated phages from environmental water samples and tested against various clinically isolated MDR spp. In this study, we have defined the isolation and detailed physical and genomic characterizations of two phages and from environmental water samples. The phages exhibited potent lytic activity against , and . They showed absorption within 5-10 min, a burst size ranging from ~74 to 265 PFU/cell, and a latent period of 5-20 min. The phages were stable at a broad pH range and survived an hour at 50°C. The purified phages and belong to the family with an isometric head (64.90 ± 2.04 nm and 62.42 ± 4.04 nm, respectively) and a non-contractile tail (145 ± 8.5 nm and 148.47 ± 14.5 nm, respectively). The analysis concluded that the size of the genomic DNA of the phage is 50,390 bp with a GC content of 44.90%, while the genome size of the phage is 50,523 bp with a GC content of 48.30%. A total of 85 and 83 putative open reading frames (ORFs) were predicted in the and phages, respectively. Furthermore, a comparative genomic and phylogenetic analysis revealed that both phages represented different isolates and novel members of the T1-like phages. and phages, either individually or in a cocktail form, showed a significant reduction in the viable count on raw chicken samples after 72 h of incubation. Therefore, these results indicate that these phages might have a potential role in therapeutic approaches designed for shigellosis patients as well as in the biological control of MDR spp. in the poultry or food industry during the course of meat storage.
多重耐药菌的证据及流行情况对全球公共卫生和经济构成了严重威胁。通过食物或水传播的多重耐药菌需要一种替代策略来应对这一威胁。在这方面,噬菌体疗法作为对抗多重耐药病原体的一种潜在方法,已引起医学从业者和研究人员的极大兴趣。在此观察中,我们从环境水样中分离出噬菌体,并对各种临床分离的多重耐药菌进行了测试。在本研究中,我们定义了从环境水样中分离出的两种噬菌体(噬菌体 和 )的详细物理和基因组特征。这些噬菌体对 、 和 表现出强大的裂解活性。它们在5 - 10分钟内开始吸附,裂解量范围为~74至265个噬菌斑形成单位/细胞,潜伏期为5 - 20分钟。这些噬菌体在较宽的pH范围内稳定,在50°C下可存活一小时。纯化后的噬菌体 和 属于 科,头部呈等轴状(分别为64.90 ± 2.04纳米和62.42 ± 4.04纳米),尾部非收缩性(分别为145 ± 8.5纳米和148.47 ± 14.5纳米)。 分析得出,噬菌体 的基因组DNA大小为50,390碱基对,GC含量为44.90%,而噬菌体 的基因组大小为50,523碱基对,GC含量为48.30%。在噬菌体 和 中分别预测到总共85个和83个推定的开放阅读框(ORF)。此外,比较基因组和系统发育分析表明,这两种噬菌体代表不同的分离株,是T1样噬菌体的新成员。噬菌体 和 单独或以混合形式在孵育72小时后,均使生鸡肉样品上的活菌数显著减少。因此,这些结果表明,这些噬菌体在针对志贺氏菌病患者的治疗方法中以及在家禽或食品工业肉类储存过程中对多重耐药菌的生物控制方面可能具有潜在作用。